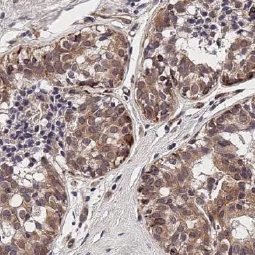
新闻图片15
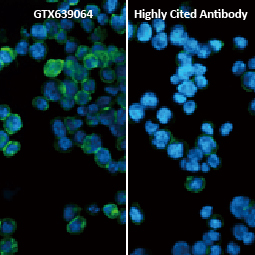
新闻图片18

文献支持
Mu Opioid receptor antibody
¥5000
推荐产品
公司新闻/正文
蛇年开运 9折抢先购!!
226 人阅读发布时间:2024-12-30 14:50

活动说明
※凡购买 6 码系列 100ul 抗体 (货号范例 GTX1xxxxx or GTX6xxxxx),全面EXTRA 10% OFF。
EXTRA 10% OFF: 在原折扣后价基础上再 9 折 (折扣码GTX10)。
※活动期间自 2025.01.01 至 2025.03.31 止。
※本内容仅限中国适用,详情请洽当地经销商或总代理欣博盛 market@neobioscience.com
※GeneTex 保有活动解释之权力。
Selected Secondary Antibodies
 |
 |
 |
| GTX213110-01 WB, IHC-P, ELISA |
GTX213110-04 WB, ICC/IF, IHC-P, IHC-Fr, IHC-Wm, FACS |
GTX213110-05 WB, ICC/IF, IHC-P, IHC-Fr, FACS |
 |
 |
 |
| GTX213111-01 WB, IHC-P, ELISA, IHC |
GTX213111-04 WB, ICC/IF, IHC-P, IHC-Fr, FACS |
GTX213111-05 WB, ICC/IF, IHC-P, IHC-Fr |
Recombinant Antibodies for Cancer Research
 |
 |
 |
 |
| HIF1 alpha antibody [HL3154] (GTX640664) |
Vimentin antibody [HL1506] (GTX636980) |
mTOR antibody [HL2216] (GTX638220) |
VEGFA antibody [HL1755] (GTX637405) |
Recombinant Antibodies for Exosome Research
 |
 |
 |
 |
| TSG101 antibody [4A10-RB] (GTX635396) |
CD81 antibody [HL1666] (GTX637264) |
Hsp70 antibody [HL1580] (GTX637059) |
Integrin beta 1 / CD29 antibody [HL1255] (GTX636657) |
Recombinant Antibodies for Immunology Research
|
 |
 |
|
| TIGIT antibody [HL2657] (GTX639116) |
TNF alpha antibody [HL1579] (GTX637058) |
CCR4 antibody [HL2481] (GTX638830) |
CXCR4 antibody [HL2612] (GTX639064) |
更多详情请联系
欣博盛生物科技
全国服务热线:4006-800-892
邮箱:market@neobioscience.com
Wechat: 13129540117
深圳:0755-26755892
北京:010-88594029
上海:021-34613729
广州:020-87615159







